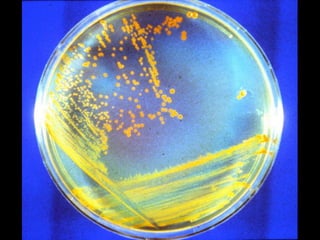

This document discusses gifted education in the 21st century and the need for change. It promotes incorporating technology, focusing on real-world problems, and developing skills like creativity, critical thinking, and communication. References are made to pioneers in gifted education from the past and promoting new literacies and a student-centered approach for the future of education.